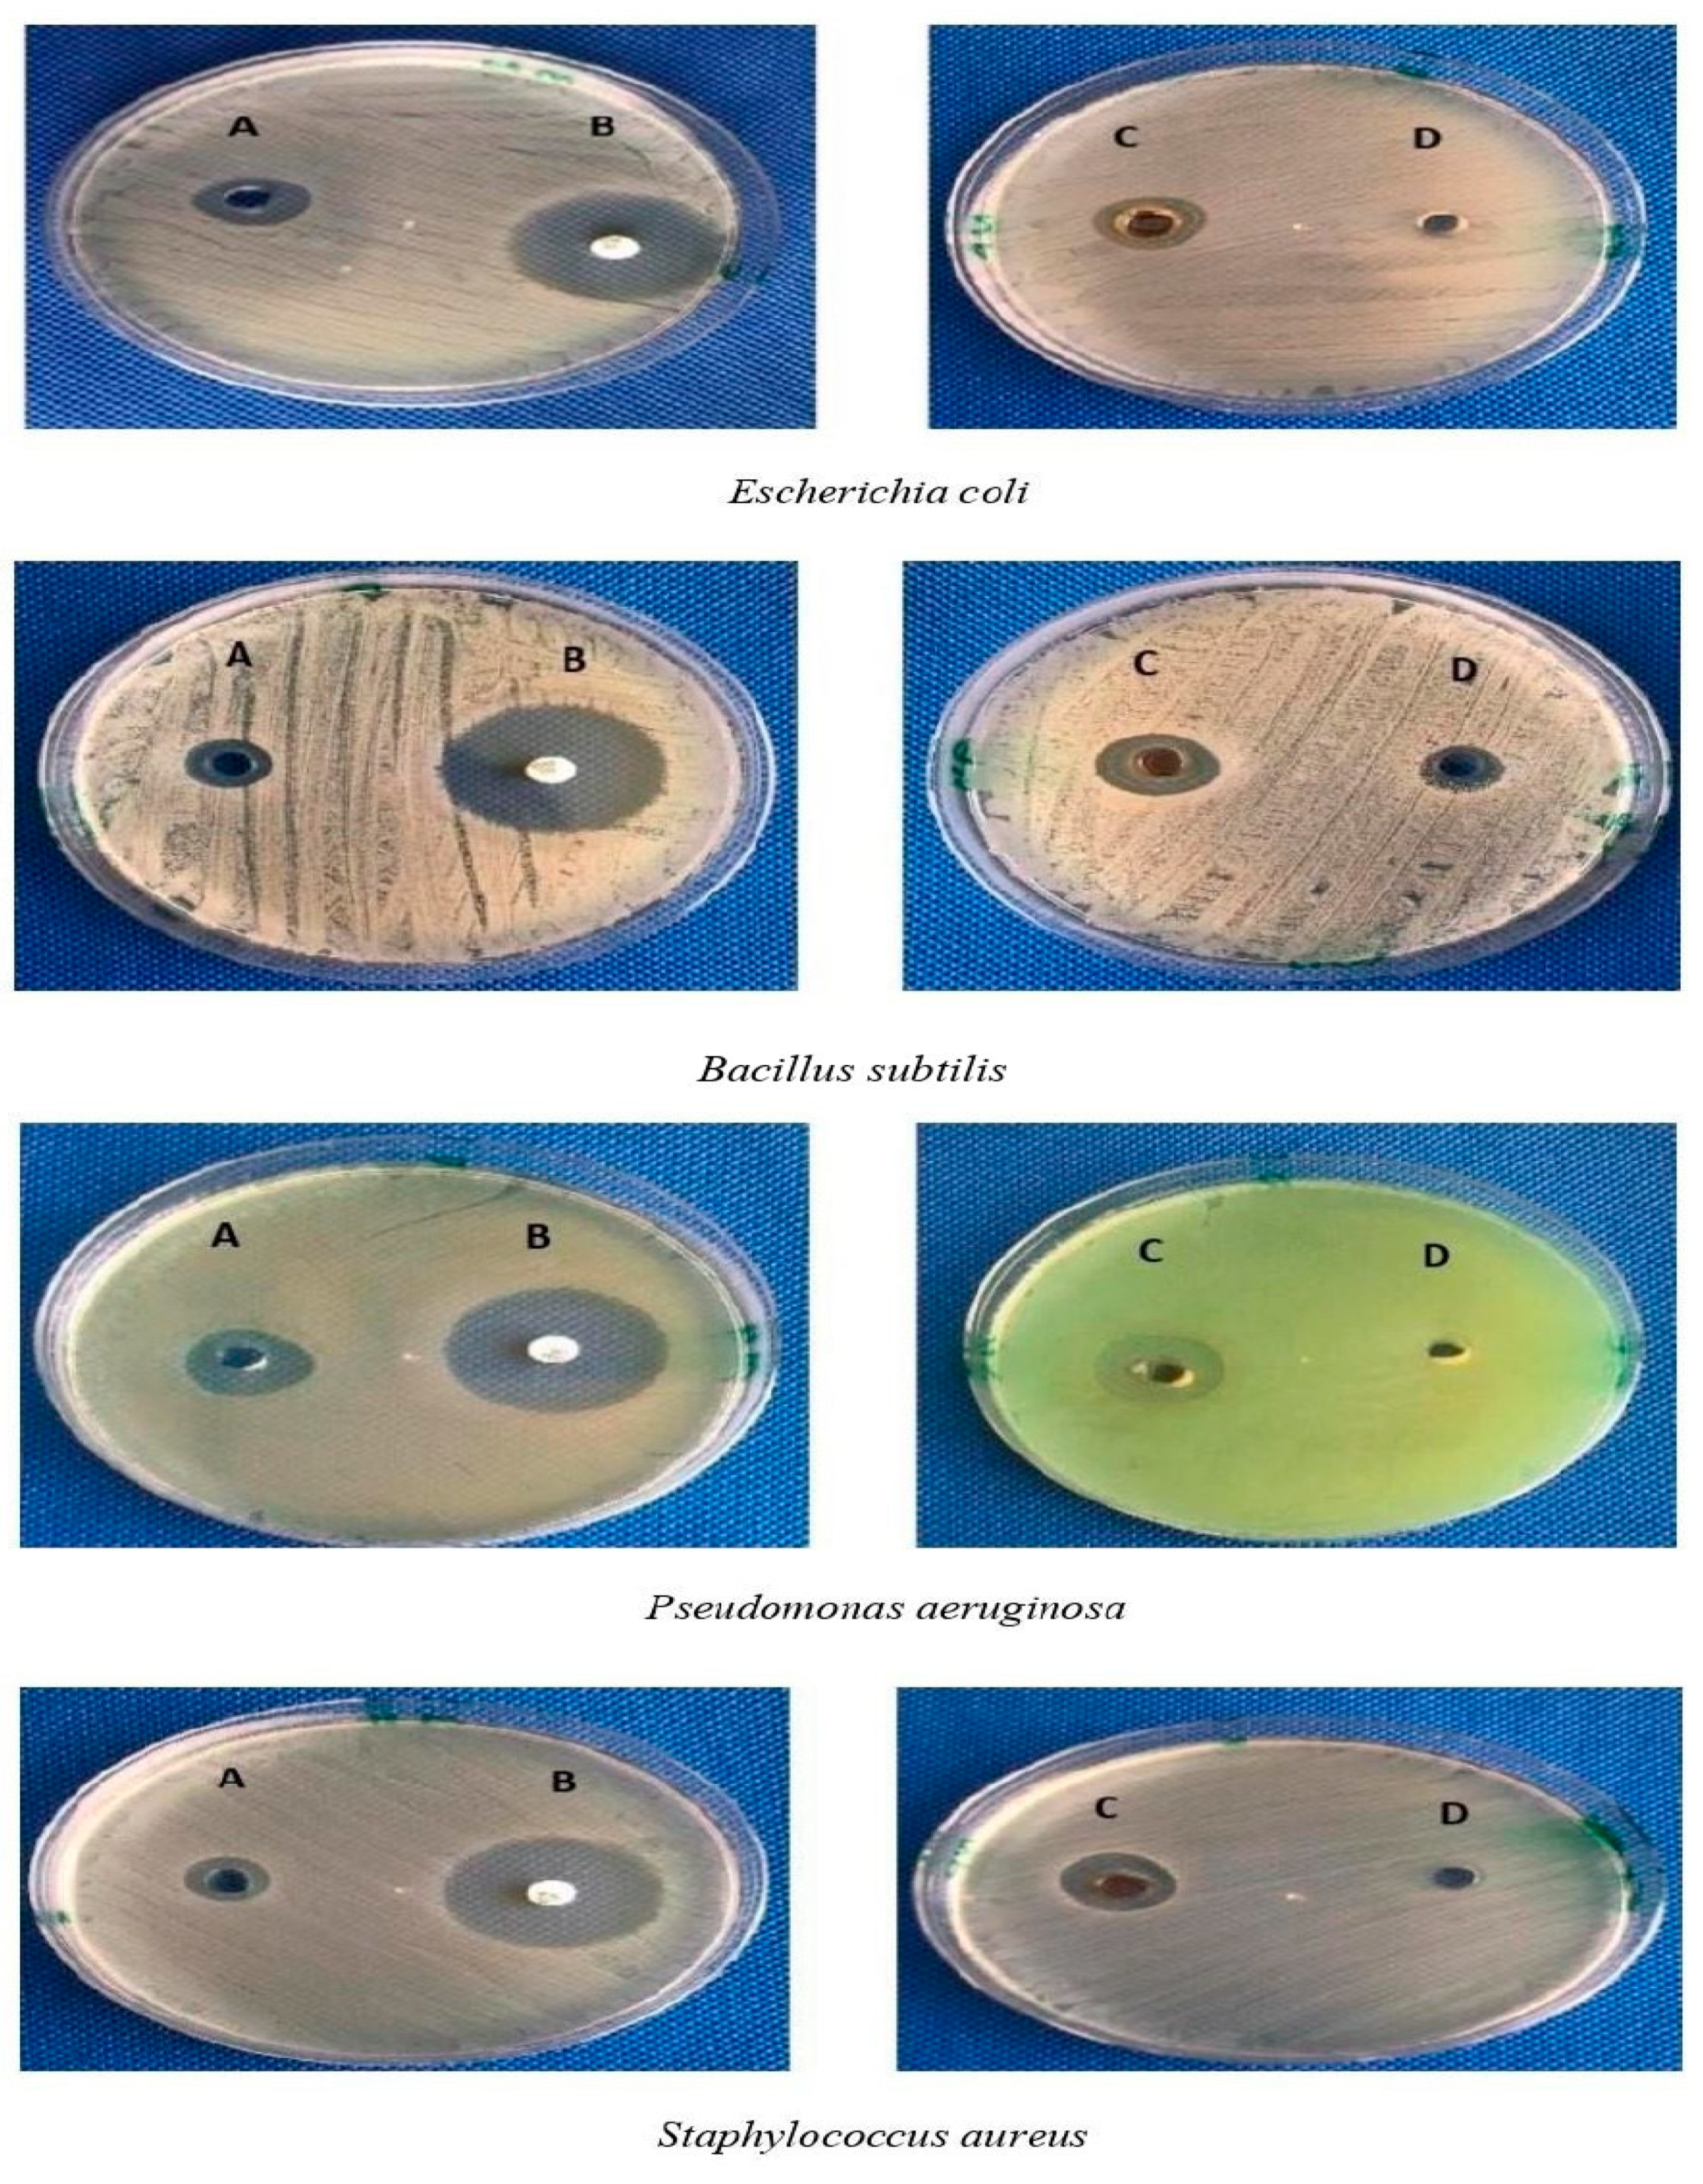
Molecules 27 02186 g010

Sunlight-Mediated Green Synthesis of Silver Nanoparticles Using the Berries of Ribes rubrum (Red Currants): Characterisation and Evaluation of Their Antifungal and Antibacterial Activities
Abstract
1. Introduction
2. Results and Discussion
2.1. Visual Examination of Nanoparticle Formation and UV–Vis Spectroscopy
2.2. FTIR Analysis (Rc Extracts and AgNPs)
2.3. Energy-Dispersive X-ray Analysis (EDX)
2.4. Size and Morphology Studies of Rc-AgNPs with TEM and DLS
2.5. Antifungal Activity of Red Currant Aqueous Extracts and Rc-AgNPs
2.6. Antibacterial Activity of Red Currant Aqueous Extracts and Rc-AgNPs
3. Materials and Methods
3.1. Plant Material and Chemicals
3.2. Microorganisms
3.3. Preparation of Red Currant (Rc) Extract
3.4. Synthesis of Silver Nanoparticles Using Aqueous Extract of Rc
3.5. Characterisation of Rc-AgNPs
3.5.1. UV–Vis Spectroscopic Analysis of Rc-AgNPs
3.5.2. Fourier Transform Infrared Spectroscopy
3.5.3. Energy-Dispersive X-ray Analysis with Field-Emission Scanning Electron Microscopy
3.5.4. The Dynamic Light Scattering Analysis
3.5.5. Transmission Electron Microscopy
3.6. Antifungal Activity
3.7. Antibacterial Activity
3.8. Statistical Analysis
4. Conclusions
Author Contributions
Funding
Institutional Review Board Statement
Informed Consent Statement
Data Availability Statement
Acknowledgments
Conflicts of Interest
Sample Availability
References
- Sharifi-Rad, M.; Pohl, P.; Epifano, F.; Álvarez-Suarez, J.M. Green Synthesis of Silver Nanoparticles using Astragalus tribuloides Delile. Root Extract: Characterization, Antioxidant, Antibacterial, and Anti-inflammatory Activities. Nanomaterials 2020, 10, 2383. [Google Scholar] [CrossRef] [PubMed]
- Mahdavi, B.; Saneei, S.; Qorbani, M.; Zhaleh, M.; Zangeneh, A.; Zangeneh, M.M.; Pirabbasi, E.; Abbasi, N.; Ghaneialvar, H. Ziziphora clinopodioides Lam leaves aqueous extract mediated synthesis of zinc nanoparticles and their antibacterial, antifungal, cytotoxicity, antioxidant, and cutaneous wound healing properties under in vitro and in vivo conditions. App. Organomet. Chem. 2019, 33, e5164. [Google Scholar] [CrossRef]
- Arunachalam, K.D.; Annamalai, S.K.; Hari, S. One-step green synthesis and characterization of leaf extract-mediated biocompatible silver and gold nanoparticles from Memecylon umbellatum. Int. J. Nanomed. 2013, 8, 1307–1315. [Google Scholar] [CrossRef] [PubMed]
- Hynes, N.R.; Sankaranarayanan, R.; Kumar, J.P. 2—Nanoparticles and medicine. Nanomed. Manuf. Appl. 2021, 21–37. [Google Scholar] [CrossRef]
- Hernández-Morales, L.; Espinoza-Gómez, H.; Flores-López, L.Z.; Sotelo-Barrera, E.L.; Núñez-Rivera, A.; Cadena-Nava, R.D.; Alonso-Núñez, G.; Espinoza, K.A. Study of the green synthesis of silver nanoparticles using a natural extract of dark or white Salvia hispanica L. seeds and their antibacterial application. Appl. Surf. Sci. 2019, 489, 952–961. [Google Scholar] [CrossRef]
- Sumbal; Nadeem, A.; Naz, S.; Ali, J.S.; Mannan, A.; Zia, M. Synthesis, characterization and biological activities of monometallic and bimetallic nanoparticles using Mirabilis jalapa leaf extract. Biotech. Rep. 2019, 22, e00338. [Google Scholar] [CrossRef]
- Dada, A.O.; Adekola, F.A.; Dada, F.E.; Adelani-Akande, A.T.; Bello, M.O.; Okonkwo, C.R.; Inyinbor, A.A.; Oluyori, A.P.; Olayanju, A.T.; Ajanaku, K.O.; et al. Silver nanoparticle synthesis by Acalypha wilkesiana extract: Phytochemical screening, characterization, influence of operational parameters, and preliminary antibacterial testing. Heliyon 2019, 5, e02517. [Google Scholar] [CrossRef]
- Shao, F.; Yang, A.; Yu, D.M.; Wang, J.; Gong, X.; Tian, H. Bio-synthesis of Barleria gibsoni leaf extract mediated zinc oxide nanoparticles and their formulation gel for wound therapy in nursing care of infants and children. J. Photochem. Photobiol. B Biol. 2018, 189, 267–273. [Google Scholar] [CrossRef]
- Mukhopadhyay, R.; Kazi, J.; Debnath, M.C. Synthesis and characterization of copper nanoparticles stabilized with Quisqualis indica extract: Evaluation of its cytotoxicity and apoptosis in B16F10 melanoma cells. Biomed. Pharmacother. 2018, 97, 1373–1385. [Google Scholar] [CrossRef]
- Arya, G.; Kumari, R.M.; Sharma, N.; Gupta, N.; Kumar, A.; Chatterjee, S.; Nimesh, S. Catalytic, antibacterial and antibiofilm efficacy of biosynthesized silver nanoparticles using Prosopis juliflora leaf extract along with their wound healing potential. J. Photochem. Photobiol. B. 2019, 190, 50–58. [Google Scholar] [CrossRef]
- LaVan, D.A.; McGuire, T.; Langer, R. Small-scale systems for in vivo drug delivery. Nat. Biotechnol. 2003, 21, 1184–1191. [Google Scholar] [CrossRef] [PubMed]
- Cavalcanti, A.; Shirinzadeh, B.; Freitas, R.A.; Hogg, T. Nanorobot architecture for medical target identification. Nanotechnology 2008, 19, 015103. [Google Scholar] [CrossRef]
- Patra, J.K.; Baek, K. Green synthesis of silver chloride nanoparticles using Prunus persica L. outer peel extract and investigation of antibacterial, anticandidal, antioxidant potential. Green Chem. Lett. Rev. 2016, 9, 132–142. [Google Scholar] [CrossRef]
- Slawson, R.M.; Trevors, J.T.; Lee, H. Silver accumulation and resistance in Pseudomonas stutzeri. Arch. Microbiol. 1992, 158, 398–404. [Google Scholar] [CrossRef]
- Zhao, G.; Stevens, S.E. Multiple parameters for the comprehensive evaluation of the susceptibility of Escherichia coli to the silver ion. Biometals 1998, 11, 27–32. [Google Scholar] [CrossRef] [PubMed]
- Okaiyeto, K.; Ojemaye, M.O.; Hoppe, H.; Mabinya, L.V.; Okoh, A.I. Phytofabrication of silver/silver chloride nanoparticles using aqueous leaf extract of Oedera genistifolia: Characterization and antibacterial potential. Molecules 2019, 24, 4382. [Google Scholar] [CrossRef] [PubMed]
- Dhayalan, M.; Denison, M.I.; Ayyar, M.; Gandhi, N.N.; Krishnan, K.; Abdulhadi, B. Biogenic synthesis, characterization of gold and silver nanoparticles from Coleus forskohlii and their clinical importance. J. Photochem. Photobiol. B 2018, 183, 251–257. [Google Scholar] [CrossRef]
- Selvan, D.A.; Mahendiran, D.; Kumar, R.S.; Rahiman, A.K. Garlic, green tea and turmeric extracts-mediated green synthesis of silver nanoparticles: Phytochemical, antioxidant and in vitro cytotoxicity studies. J. Photochem. Photobiol. B 2018, 180, 243–252. [Google Scholar] [CrossRef]
- Fatima, R.; Priya, M.; Indurthi, L.; Radhakrishnan, V.; Sudhakaran, R. Biosynthesis of silver nanoparticles using red algae Portieria hornemannii and its antibacterial activity against fish pathogens. Microb. Pathog. 2019, 138, 103780. [Google Scholar] [CrossRef]
- Shankar Naik, B. Biosynthesis of Silver Nanoparticles from Endophytic Fungi and Their Role in Plant Disease Management. In Microbial Endophytes, 1st ed.; Kumar, A., Radhakrishnan, E.K., Eds.; Woodhead Publishing: Sawston, UK, 2020; pp. 307–321. ISBN 9780128196540. [Google Scholar] [CrossRef]
- Kabeerdass, N.; Al Otaibi, A.; Rajendran, M.; Manikandan, A.; Kashmery, H.A.; Rahman, M.M.; Madhu, P.; Khan, A.; Asiri, A.M.; Mathanmohun, M. Bacillus-mediated silver nanoparticle synthesis and Its antagonistic activity against bacterial and fungal pathogens. Antibiotics 2021, 10, 1334. [Google Scholar] [CrossRef]
- Logeswari, P.; Silambarasan, S.; Abraham, J. Ecofriendly synthesis of silver nanoparticles from commercially available plant powders and their antibacterial properties. Sci. Iran. 2013, 20, 1049–1054. [Google Scholar] [CrossRef]
- Cittrarasu, V.; Kaliannan, D.; Dharman, K.; Maluventhen, V.; Easwaran, M.; Liu, W.; Balasubramanian, B.; Arumugam, M. Green synthesis of selenium nanoparticles mediated from Ceropegia bulbosa Roxb extract and its cytotoxicity, antimicrobial, mosquitocidal and photocatalytic activities. Sci. Rep. 2021, 11, 1032. [Google Scholar] [CrossRef] [PubMed]
- He, Y.; Wei, F.; Ma, Z.; Zhang, H.; Yang, Q.; Yao, B.; Huang, Z.; Li, J.; Zeng, C.; Zhang, Q. Green synthesis of silver nanoparticles using seed extract of Alpinia katsumadai, and their antioxidant, cytotoxicity, and antibacterial activities. RSC Adv. 2017, 7, 39842–39851. [Google Scholar] [CrossRef]
- Mangindaan, D.; Lin, G.; Kuo, C.; Chien, H. Biosynthesis of silver nanoparticles as catalyst by spent coffee ground/recycled poly(ethylene terephthalate) composites. Food Bioprod. Process. 2020, 121, 193–201. [Google Scholar] [CrossRef]
- Rizwana, H.; Bokahri, N.A.; Alkhattaf, S.F.; Albasher, G.; Aldehaish, A.H. Antifungal, Antibacterial, and Cytotoxic Activities of Silver Nanoparticles Synthesized from Aqueous Extracts of Mace-Arils of Myristica fragrans. Molecules 2021, 26, 7709. [Google Scholar] [CrossRef]
- Heydari, R.; Rashidipour, M. Green Synthesis of Silver Nanoparticles Using Extract of Oak Fruit Hull (Jaft): Synthesis and In Vitro Cytotoxic Effect on MCF-7 Cells. Int. J. Breast Cancer 2015, 2015, 846743. [Google Scholar] [CrossRef]
- Vorobyova, V.I.; Vasyliev, G.S.; Skiba, M.I. Eco-friendly “green” synthesis of silver nanoparticles with the black currant pomace extract and its antibacterial, electrochemical, and antioxidant activity. Appl. Nanosci. 2020, 10, 4523–4534. [Google Scholar] [CrossRef]
- Devanesan, S.; AlSalhi, M.S. Green Synthesis of Silver Nanoparticles Using the Flower Extract of Abelmoschus esculentus for Cytotoxicity and Antimicrobial Studies. Int. J. Nanomed. 2021, 16, 3343–3356. [Google Scholar] [CrossRef]
- Mahiuddin, M.; Saha, P.; Ochiai, B. Green Synthesis and Catalytic Activity of Silver Nanoparticles Based on Piper chaba Stem Extracts. Nanomaterials 2020, 10, 1777. [Google Scholar] [CrossRef]
- Behravan, M.; Panahi, A.H.; Naghizadeh, A.; Ziaee, M.; Mahdavi, R.; Mirzapour, A. Facile green synthesis of silver nanoparticles using Berberis vulgaris leaf and root aqueous extract and its antibacterial activity. Int. J. Biol. Macromol. 2019, 124, 148–154. [Google Scholar] [CrossRef]
- Rizwana, H.; Alwhibi, M.S.; Aldarsone, H.A.; Awad, M.A.; Soliman, D.A.; Bhat, R.S. Green synthesis, characterization, and antimicrobial activity of silver nanoparticles prepared using Trigonella foenum-graecum L. leaves grown in Saudi Arabia. Green Process. Synth. 2021, 10, 421–429. [Google Scholar] [CrossRef]
- Erci, F.; Cakir-Koc, R.; Isildak, I. Green synthesis of silver nanoparticles using Thymbra spicata L. var. spicata (zahter) aqueous leaf extract and evaluation of their morphology-dependent antibacterial and cytotoxic activity. Artl. Cells Nanomed. Biotechnol. 2018, 46, 150–158. [Google Scholar] [CrossRef]
- Rehana, D.; Mahendiran, D.; Kumar, R.S.; Rahiman, A.K. Evaluation of antioxidant and anticancer activity of copper oxide nanoparticles synthesized using medicinally important plant extracts. Biomed. Pharmacother. 2017, 89, 1067–1077. [Google Scholar] [CrossRef] [PubMed]
- Rizwana, H.; Alwhibi, M.S. Biosynthesis of silver nanoparticles using leaves of Mentha pulegium, their characterization, and antifungal properties. Green Process. Synth. 2021, 10, 824–834. [Google Scholar] [CrossRef]
- Ghannoum, M.A.; Rice, L.B. Antifungal agents: Mode of action, mechanisms of resistance, and correlation of these mechanisms with bacterial resistance. Clin. Microbiol. Rev. 1999, 12, 501–517. [Google Scholar] [CrossRef]
- Cowen, L.E.; Sanglard, D.; Howard, S.J.; Rogers, P.D.; Perlin, D.S. Mechanisms of Antifungal Drug Resistance. Cold Spring Harb. Perspect. Med. 2014, 5, a019752. [Google Scholar] [CrossRef]
- Subramani, R.; Narayanasamy, M.; Feussner, K.D. Plant-derived antimicrobials to fight against multi-drug-resistant human pathogens. 3 Biotech 2017, 7, 172. [Google Scholar] [CrossRef]
- Sinnott, Q.P. A revision of Ribes L. subg. Grossularia (Mill.) pers. Sect. Grossularia (Mill.) Nutt. (Grossulariaceae) in North America. Rhodora 1985, 87, 189–286. Available online: http://www.jstor.org/stable/23314591 (accessed on 22 March 2022).
- Milivojevik, J.; Slatnar, A.; Mikulic-Petkovsek, M.; Stampar, F.; Nikolic, M.; Veberic, R. The influence of early yield on the accumulation of major taste and health-related compounds in black and red currant cultivars (Ribes spp.). J. Agric. Food Chem. 2012, 60, 2682–2691. [Google Scholar] [CrossRef]
- Miladinović, B.; Kostić, M.; Šavikin, K.; Đorđević, B.; Mihajilov-Krstev, T.; Živanović, S.; Kitić, D. Chemical profile and antioxidative and antimicrobial activity of juices and extracts of 4 black currants varieties (Ribes nigrum L.). J. Food Sci. 2014, 79, C301–C309. [Google Scholar] [CrossRef]
- Laczkó-Zöld, E.; Komlósi, A.; Ülkei, T.; Fogarasi, E.; Croitoru, M.; Fülöp, I.; Domokos, E.; Ştefănescu, R.; Varga, E. Extractability of polyphenols from black currant, red currant and gooseberry and their antioxidant activity. Acta Biol. Hung. 2018, 69, 156–169. [Google Scholar] [CrossRef] [PubMed]
- Mitić, M.N.; Obradović, M.V.; Kostić, D.A.; Micić, R.J.; Paunović, D.Đ. Phenolic profile and antioxidant capacities of dried red currant from Serbia, extracted with different solvent. Food Sci. Biotechnol. 2011, 20, 1625–1631. [Google Scholar] [CrossRef]
- Knekt, P.; Jarvinen, R.; Reunanen, A.; Maatela, J. Flavonoid intake and coronary mortality in Finland: A cohort study. BMJ 1996, 312, 478–481. [Google Scholar] [CrossRef] [PubMed]
- Seeram, N.P.; Zhang, Y.; Nair, M.G. Inhibition of proliferation of human cancer cells and cyclooxygenase enzymes by anthocyanidins and catechins. Nutr. Cancer 2003, 46, 101–106. [Google Scholar] [CrossRef]
- Tits, M.; Angenot, L.; Damas, J.; Dierckxsens, Y.; Poukens, P. Anti-inflammatory prodelphinidins from black currant (Ribes nigrum) leaves. Planta Med. 1991, 57, A134. [Google Scholar] [CrossRef]
- Delazar, A.; Lasheni, S.; Fathi-Azad, F.; Nahar, L.; Rahman, M.M.; Asnaashari, S.; Mojarab, M.; Sarker, S.D. Free-radical scavenging flavonol 3-O-glycosides from the leaves of Ribes biebersteinii Berl. Rec. Nat. Prod. 2010, 4, 96–100. [Google Scholar]
- Takata, R.; Yamamoto, R.; Yanai, T.; Konno, T.; Okubo, T. Immunostimulatory effects of a polysaccharide-rich substance with antitumor activity isolated from black currant (Ribes nigrum L.). Biosci. Biotechnol. Biochem. 2005, 69, 2042–2050. [Google Scholar] [CrossRef][Green Version]
- Krisch, J.; Ördögh, L.; Galgóczy, L.; Papp, T.; Vágvölgyi, C. Anticandidal effect of berry juices and extracts from Ribes species. Cent. Eur. J. Biol. 2009, 4, 86–89. [Google Scholar] [CrossRef]
- Kim, J.; Sa, Y.J.; Hyun, T.K.; Kim, M. Comparison of biological activities of Ribes fasciculatum according to regional differences. J. Med. Plant Res. 2011, 5, 4771–4779. [Google Scholar] [CrossRef]
- Kumar, V.; Bano, D.; Mohan, S.M.; Singh, D.K.; Hasan, S.H. Sunlight-induced green synthesis of silver nanoparticles using aqueous leaf extract of Polyalthia longifolia and its antioxidant activity. Mater. Lett. 2016, 181, 371–377. [Google Scholar] [CrossRef]
- Krishnaraj, C.; Jagan, E.G.; Rajasekar, S.; Selvakumar, P.M.; Kalaichelvan, P.T.; Mohan, N. Synthesis of silver nanoparticles using Acalypha indica leaf extracts and its antibacterial activity against water borne pathogens. Colloids Surf. B Biointerfaces 2010, 76, 50–56. [Google Scholar] [CrossRef] [PubMed]
- Bahuguna, G.; Kumar, A.; Mishra, N.K.; Kumar, C.N.; Bahlwa, A.; Chaudhary, P.; Singh, R. Green synthesis and characterization of silver nanoparticles using aqueous petal extract of the medicinal plant Combretum indicum. Mater. Res. Exp. 2016, 3, 075003. [Google Scholar] [CrossRef]
- Sooraj, M.P.; Nair, A.S.; Vineetha, D. Sunlight-mediated green synthesis of silver nanoparticles using Sida retusa leaf extract and assessment of its antimicrobial and catalytic activities. Chem. Pap. 2021, 75, 351–363. [Google Scholar] [CrossRef]
- Nguyen, V.T. Sunlight-Driven synthesis of silver nanoparticles using Pomelo peel extract and antibacterial testing. J. Chem. 2020, 2020, 6407081. [Google Scholar] [CrossRef]
- Mathew, S.; Prakash, A.; Radhakrishnan, E.K. Sunlight mediated rapid synthesis of small size range silver nanoparticles using Zingiber officinale rhizome extract and its antibacterial activity analysis. Inorg. Nano-Met. Chem. 2018, 48, 139–145. [Google Scholar] [CrossRef]
- Mallick, K.; Witcomb, M.J.; Scurrell, M.S. Polymer stabilized silver nanoparticles: A photochemical synthesis route. J. Mater. Sci. 2004, 39, 4459–4463. [Google Scholar] [CrossRef]
- Prathna, T.C.; Raichur, A.M.; Chandrasekaran, N.; Mukherjee, A. Sunlight irradiation induced green synthesis of stable silver nanoparticles using Citrus limon extract. Proc. Natl. Acad. Sci. India Sect. B Biol. Sci. 2013, 84, 65–70. [Google Scholar] [CrossRef]
- Yang, N.; Wei, X.; Li, W. Sunlight irradiation induced green synthesis of silver nanoparticles using peach gum polysaccharide and colorimetric sensing of H2O2. Mater. Lett. 2015, 154, 21–24. [Google Scholar] [CrossRef]
- Jayapriya, M.G.; Dhanasekaran, D.; Arulmozhi, M.; Nandhakumar, E.; Senthilkumar, N.; Sureshkumar, K. Green synthesis of silver nanoparticles using Piper longum catkin extract irradiated by sunlight: Antibacterial and catalytic activity. Res. Chem. Intermed. 2019, 45, 3617–3631. [Google Scholar] [CrossRef]
- Vasyliev, G.S.; Vorobyova, V.I.; Skiba, M.I.; Khrokalo, L. Green synthesis of silver nanoparticles using waste products (Apricot and Black Currant Pomace) aqueous extracts and their characterization. Adv. Mater. Sci. Eng. 2020, 2020, 4505787. [Google Scholar] [CrossRef]
- Sre, P.R.; Reka, M.; Poovazhagi, R.; Kumar, M.A.; Murugesan, K. Antibacterial and cytotoxic effect of biologically synthesized silver nanoparticles using aqueous root extract of Erythrina indica lam. Spectrochim. Acta A Mol. Biomol. Spectrosc. 2015, 135, 1137–1144. [Google Scholar] [CrossRef]
- Aslany, S.; Tafvizi, F.; Naseh, V. Characterization and evaluation of cytotoxic and apoptotic effects of green synthesis of silver nanoparticles using Artemisia ciniformis on human gastric adenocarcinoma. Mater. Today Commun. 2020, 24, 101011. [Google Scholar] [CrossRef]
- Balakrishnan, S.; Sivaji, I.; Kandasamy, S.; Duraisamy, S.; Kumar, N.S.; Gurusubramanian, G. Biosynthesis of silver nanoparticles using Myristica fragrans seed (nutmeg) extract and its antibacterial activity against multidrug-resistant (MDR) Salmonella enterica serovar Typhi isolates. Environ. Sci. Pollut. Res. 2017, 24, 14758–14769. [Google Scholar] [CrossRef] [PubMed]
- Zuorro, A.; Iannone, A.; Natali, S.; Lavecchia, R. Green synthesis of silver nanoparticles using bilberry and red currant waste extracts. Processes 2019, 7, 193. [Google Scholar] [CrossRef]
- Bhutto, A.A.; Kalay, S.; Sherazi, S.T.H.; Culha, M. Quantitative structure–activity relationship between antioxidant capacity of phenolic compounds and the plasmonic properties of silver nanoparticles. Talanta 2018, 189, 174–181. [Google Scholar] [CrossRef]
- Liu, Y.; Chang, Y.; Chen, H. Silver nanoparticle biosynthesis by using phenolic acids in rice husk extract as reducing agents and dispersants. J. Food Drug Anal. 2018, 26, 649–656. [Google Scholar] [CrossRef]
- Yoosaf, K.; Ipe, B.I.; Suresh, C.H.; Thomas, K.G. In situ synthesis of metal nanoparticles and selective naked-eye detection of lead ions from aqueous media. J. Phys. Chem. C 2007, 111, 12839–12847. [Google Scholar] [CrossRef]
- Al-Kurdy, M.J.; Khudair, K.K.; Al-Kinani, L.H. Synthesis and characterization of black currant selenium nanoparticles (Part I). Iraqi J. Vet. Med. 2020, 44, 25–34. [Google Scholar] [CrossRef]
- Stursa, V.; Divis, P.; Jureckova, Z.; Matejicek, A. Analysis of red currant (Ribes rubrum) and red gooseberry (Ribes uva-crispa) varieties by inductively coupled plasma atomic emission spectroscopy. MendelNet 2016, 23, 669–674. [Google Scholar]
- Chien, H.W.; Kuo, C.J.; Kao, L.H.; Lin, G.Y.; Chen, P.Y. Polysaccharidic spent coffee grounds for silver nanoparticle immobilization as a green and highly efficient biocide. Int. J. Biol. Macromol. 2019, 140, 168–176. [Google Scholar] [CrossRef]
- Bhanumathi, R.; Vimala, K.; Shanthi, K.; Thangaraj, R.; Kannan, S. Bioformulation of silver nanoparticles as berberine carrier cum anticancer agent against breast cancer. New J. Chem. 2017, 41, 14466–14477. [Google Scholar] [CrossRef]
- Zhou, G.; Yang, J.C. In situ UHV-TEM investigation of the kinetics of initial stages of oxidation on the roughened Cu (110) surface. Surf. Sci. 2004, 559, 100–110. [Google Scholar] [CrossRef]
- Bhattacharjee, S. DLS and zeta potential—What they are and what they are not? J. Control Release 2016, 235, 337–351. [Google Scholar] [CrossRef]
- Satoh, A.; Chantrell, R.W.; Coverdale, G.N. Brownian dynamics simulations of ferromagnetic colloidal dispersions in a simple shear flow. J. Coll. Interface Sci. 1999, 209, 44–59. [Google Scholar] [CrossRef]
- Dalstein, L.; Haddada, M.B.; Barbillon, G.; Humbert, C.; Tadjeddine, A.; Boujday, S.; Busson, B. Revealing the interplay between adsorbed molecular layers and gold nanoparticles by linear and nonlinear optical properties. J. Phys. Chem. C 2015, 119, 17146–17155. [Google Scholar] [CrossRef]
- Liu, W.B.; Rose, J.; Plantevin, S.; Auffan, M.; Bottero, J.Y.; Vidaud, C. Protein corona formation for nanomaterials and proteins of a similar size: Hard or soft corona? Nanoscale 2013, 5, 1658–1668. [Google Scholar] [CrossRef] [PubMed]
- Fan, X.; Zheng, W.; Singh, D.J. Light scattering and surface plasmons on small spherical particles. Light Sci. Appl. 2014, 3, e179. [Google Scholar] [CrossRef]
- Dobrucka, R.; Długaszewska, J.; Kaczmarek, M. Antimicrobial and cytostatic activity of biosynthesized nanogold prepared using fruit extract of Ribes nigrum. Arab. J. Chem. 2016, 12, 3902–3910. [Google Scholar] [CrossRef]
- Kendir, G.; Köroglu, A.; Özkan, S.; Özgacar, S.Ö.; Karaoglu, T.; Sepander, G. Evaluation of antiviral and antimicrobial activities of Ribes species growing in Turkey. J. Biol. Act. Prod. Nat. 2016, 6, 136–149. [Google Scholar] [CrossRef]
- Paunović, S.M.; Mašković, P.; Nikolić, M.; Miletić, R. Bioactive compounds and antimicrobial activity of black currant (Ribes nigrum L.) berries and leaves extract obtained by different soil management system. Sci. Hortic. 2017, 222, 69–75. [Google Scholar] [CrossRef]
- Hirpara, D.G.; Gajera, H. Green synthesis and antifungal mechanism of silver nanoparticles derived from chitin- induced exometabolites of Trichoderma interfusant. Appl. Organomet. Chem. 2019, 34, e5407. [Google Scholar] [CrossRef]
- Li, W.; Xie, X.; Shi, Q.; Zeng, H.; Ouyang, Y.; Chen, Y. Antibacterial activity and mechanism of silver nanoparticles on Escherichia coli. Appl. Microbiol. Biotechnol. 2010, 85, 1115–1122. [Google Scholar] [CrossRef] [PubMed]
- Kumari, M.S.; Giri, V.P.; Pandey, S.; Kumar, M.; Katiyar, R.S.; Nautiyal, C.S.; Mishra, A. An insight into the mechanism of antifungal activity of biogenic nanoparticles than their chemical counterparts. Pestic. Biochem. Physiol. 2019, 157, 45–52. [Google Scholar] [CrossRef] [PubMed]
- Kim, K.; Sung, W.S.; Suh, B.K.; Moon, S.K.; Choi, J.S.; Kim, J.G.; Lee, D.G. Antifungal activity and mode of action of silver nano-particles on Candida albicans. Biometals 2009, 22, 235–242. [Google Scholar] [CrossRef]
- Kranz, S.; Guellmar, A.; Olschowsky, P.; Tonndorf-Martini, S.; Heyder, M.; Pfister, W.; Reise, M.; Sigusch, B. Antimicrobial Effect of Natural Berry Juices on Common Oral Pathogenic Bacteria. Antibiotics 2020, 9, 533. [Google Scholar] [CrossRef]
- Meikle, T.G.; Dyett, B.P.; Strachan, J.B.; White, J.; Drummond, C.J.; Conn, C.E. Preparation, characterization, and antimicrobial activity of cubosome encapsulated metal nanocrystals. ACS Appl. Mater. Interfaces 2020, 12, 6944–6954. [Google Scholar] [CrossRef]
- Chatterjee, T.; Chatterjee, B.K.; Majumdar, D.; Chakrabarti, P. Antibacterial effect of silver nanoparticles and the modeling of bacterial growth kinetics using a modified Gompertz model. Biochim. Biophys. Acta 2015, 1850, 299–306. [Google Scholar] [CrossRef]
- Qing, Y.; Cheng, L.; Li, R.; Liu, G.; Zhang, Y.; Tang, X.; Wang, J.; Liu, H.; Qin, Y. Potential antibacterial mechanism of silver nanoparticles and the optimization of orthopedic implants by advanced modification technologies. Int. J. Nanomed. 2018, 13, 3311–3327. [Google Scholar] [CrossRef]
- Klueh, U.; Wagner, V.E.; Kelly, S.; Johnson, A.; Bryers, J.D. Efficacy of silver-coated fabric to prevent bacterial colonization and subsequent device-based biofilm formation. J. Biomed. Mater. Res. 2000, 53, 621–631. [Google Scholar] [CrossRef]
- Holt, K.B.; Bard, A.J. Interaction of silver(I) ions with the respiratory chain of Escherichia coli: An electrochemical and scanning electrochemical microscopy study of the antimicrobial mechanism of micromolar Ag+. Biochemistry 2005, 44, 13214. [Google Scholar] [CrossRef]
- Schreurs, W.J.; Rosenberg, H. Effect of silver ions on transport and retention of phosphate by Escherichia coli. J. Bacteriol. 1982, 152, 7–13. [Google Scholar] [CrossRef] [PubMed]
- Hatchett, D.W.; White, H.S. Electrochemistry of sulfur adlayers on the low-index faces of silver. J. Phys. Chem. 1996, 100, 9854–9859. [Google Scholar] [CrossRef]
- Monteiro, D.R.; Gorup, L.F.; Takamiya, A.S.; de Camargo, E.R.; Filho, A.C.; Barbosa, D.B. Silver distribution and release from an antimicrobial denture base resin containing silver colloidal nanoparticles. J. Prosthodont. 2012, 21, 7–15. [Google Scholar] [CrossRef] [PubMed]
- Seong, M.S.; Lee, D.G. Silver nanoparticles against Salmonella enterica serotype typhimurium: Role of inner membrane dysfunction. Curr. Microbiol. 2017, 74, 661–670. [Google Scholar] [CrossRef]
- Khalandi, B.; Asadi, N.; Milani, M.; Davaran, S.; Abadi, E.; Akbarzadeh, A. A review on potential role of silver nanoparticles and possible mechanisms of their actions on bacteria. Drug Res. 2017, 67, 70–76. [Google Scholar] [CrossRef]
- Paredes-López, O.; Cervantes-Ceja, M.L.; Vigna-Pérez, M.; Hernández-Pérez, T. Berries: Improving Human Health and Healthy Aging, and Promoting Quality Life—A Review. Plant Foods Hum. Nutr. 2010, 65, 299–308. [Google Scholar] [CrossRef]
- Zdunić, G.; Šavikin, K.; Pljevljakušić, D.; Djordjević, B. Chapter 5—Black (Ribes nigrum L.) and Red Currant (Ribes rubrum L.) Cultivars. In Nutritional Composition of Fruit Cultivars; Monique, S.J., Preedy, V.R., Eds.; Academic Press: Waltman, MA, USA, 2016; pp. 101–126. ISBN 9780124081178. [Google Scholar] [CrossRef]
- Raudsepp, P.; Kaldmäe, H.; Kikas, A.A.; Libek, A.; Püssa, T. Nutritional quality of berries and bioactive compounds in the leaves of black currant (Ribes nigrum L.) cultivars evaluated in Estonia. J. Berry Res. 2010, 1, 53–59. [Google Scholar] [CrossRef]
- Puupponen-Pimiaä, R.; Nohynek, L.J.; Meier, C.; Kahkonen, M.P.; Heinonen, M.I.; Hopia, A.I.; Oksman-Caldentey, K. Antimicrobial properties of phenolic compounds from berries. J. Appl. Microbiol. 2001, 90, 494–507. [Google Scholar] [CrossRef]
- Bendokas, V.; Šarkinas, A.; Jasinauskienë, D.; Anisimovienë, N.; Morkûnaitë-Haimi, Š.; Stanys, V.; Šikšnianas, T. Antimicrobial activity of berries extracts of four Ribes species, their phenolic content and anthocyanin composition. Folia Hortic. 2018, 30, 249–257. [Google Scholar] [CrossRef]
- Babaoğlu, A.S.; Unal, K.; Dilek, N.M.; Poçan, H.B.; Karakaya, M. Antioxidant and antimicrobial effects of blackberry, black chokeberry, blueberry, and red currant pomace extracts on beef patties subject to refrigerated storage. Meat Sci. 2022, 187, 108765. [Google Scholar] [CrossRef]
- Maqbool, Q.; Nazar, M.; Naz, S.; Hussain, T.; Jabeen, N.; Kausar, R.; Anwaar, S.; Abbas, F.; Jan, T. Antimicrobial potential of green synthesized CeO2 nanoparticles from Olea europaea leaf extract. Int. J. Nanomed. 2016, 11, 5015–5025. [Google Scholar] [CrossRef] [PubMed]
- Vanlalveni, C.; Lallianrawna, S.; Biswas, A.; Selvaraj, M.; Changmai, B.; Rokhum, S.L. Green synthesis of silver nanoparticles using plant extracts and their antimicrobial activities: A review of recent literature. RSC Adv. 2021, 11, 2804–2837. [Google Scholar] [CrossRef]
- Chandra, H.; Kumari, P.; Bontempi, E.; Yadav, S. Medicinal plants: Treasure trove for green synthesis of metallic nanoparticles and their biomedical applications. Biocatal. Agric. Biotechnol. 2020, 24, 101518. [Google Scholar] [CrossRef]
- Augustine, R.; Hasan, A. Emerging applications of biocompatible phytosynthesized metal/metal oxide nanoparticles in healthcare. J. Drug Deliv. Sci. Technol. 2020, 56, 101516. [Google Scholar] [CrossRef]
- Rauha, J.P.; Remes, S.T.; Heinonen, M.I.; Hopia, A.I.; Kähkönen, M.P.; Kujala, T.; Pihlaja, K.; Vuorela, H.J.; Vuorela, P.M. Antimicrobial effects of Finnish plant extracts containing flavonoids and other phenolic compounds. Int. J. Food Microbiol. 2000, 56, 3–12. [Google Scholar] [CrossRef]

Publisher’s Note: MDPI stays neutral with regard to jurisdictional claims in published maps and institutional affiliations. |
© 2022 by the authors. Licensee MDPI, Basel, Switzerland. This article is an open access article distributed under the terms and conditions of the Creative Commons Attribution (CC BY) license (https://creativecommons.org/licenses/by/4.0/).
Share and Cite
Rizwana, H.; Alwhibi, M.S.; Al-Judaie, R.A.; Aldehaish, H.A.; Alsaggabi, N.S. Sunlight-Mediated Green Synthesis of Silver Nanoparticles Using the Berries of Ribes rubrum (Red Currants): Characterisation and Evaluation of Their Antifungal and Antibacterial Activities. Molecules 2022, 27, 2186. https://doi.org/10.3390/molecules27072186
Rizwana H, Alwhibi MS, Al-Judaie RA, Aldehaish HA, Alsaggabi NS. Sunlight-Mediated Green Synthesis of Silver Nanoparticles Using the Berries of Ribes rubrum (Red Currants): Characterisation and Evaluation of Their Antifungal and Antibacterial Activities. Molecules. 2022; 27(7):2186. https://doi.org/10.3390/molecules27072186
Chicago/Turabian StyleRizwana, Humaira, Mona S. Alwhibi, Rawan A. Al-Judaie, Horiah A. Aldehaish, and Noura S. Alsaggabi. 2022. "Sunlight-Mediated Green Synthesis of Silver Nanoparticles Using the Berries of Ribes rubrum (Red Currants): Characterisation and Evaluation of Their Antifungal and Antibacterial Activities" Molecules 27, no. 7: 2186. https://doi.org/10.3390/molecules27072186
APA StyleRizwana, H., Alwhibi, M. S., Al-Judaie, R. A., Aldehaish, H. A., & Alsaggabi, N. S. (2022). Sunlight-Mediated Green Synthesis of Silver Nanoparticles Using the Berries of Ribes rubrum (Red Currants): Characterisation and Evaluation of Their Antifungal and Antibacterial Activities. Molecules, 27(7), 2186. https://doi.org/10.3390/molecules27072186

